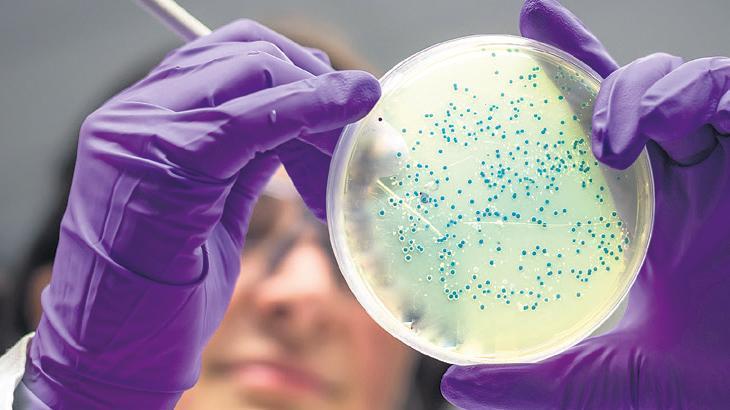

İstanbul,
11°C
parçalı az bulutlu
Ölümcül bakterilerden bazılarının insan kanını arayıp beslendiği keşfedildi.
Washington Eyalet Üniversitesi’ndeki araştırmacılar, gıda kaynaklı hastalıklara neden olan Salmonella ve E. coli gibi bakteriler arasında “bakteriyel vampirizm” adı verilen yeni bir özelliği ortaya çıkardı. Araştırmaya göre, E. coli ve Salmonella gibi bakteriler, bağırsaklardaki ve sindirim sistemindeki küçük kesiklerden kan dolaşımına girip, ölüme neden olabiliyor.